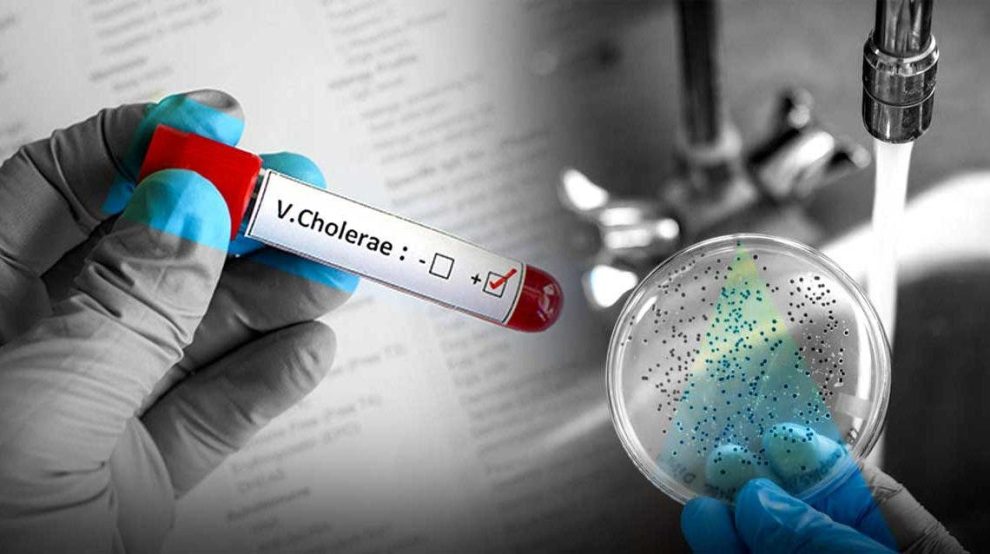
8923794064.png

Este contenido fue hecho con la asistencia de una inteligencia artificial y contó con la revisión del editor/periodista.
Santiago, RD.- A causa del reciente repunte del cólera en el vecino Haití, las autoridades sanitarias dominicanas han fortalecido los controles en el cruce fronterizo de Dajabón, con el propósito de contener la posible diseminación de esta patología. A partir de este jueves, inspectores del Ministerio de Salud Pública (MSP) se encuentran concentrados en el puente limítrofe, ejecutando rigurosos protocolos de salubridad.
La titular provincial de Salud Pública, la doctora Zabeikis Rodríguez, informó que se han puesto en marcha disposiciones como la restricción al ingreso de comidas preparadas provenientes de Haití, puesto que estas representan un foco de infección para el “Vibrio cholerae”, el microorganismo que origina el cólera.
Adicionalmente, se están entregando materiales didácticos impresos, tanto en lengua española como en creole, con el objetivo de concienciar a las comunidades sobre el valor fundamental de las prácticas preventivas.
Rodríguez hizo énfasis en que la pulcritud y la formación sanitaria resultan pilares esenciales para combatir esta enfermedad. Recomendó la higienización constante o frecuente de las manos, la utilización de soluciones cloradas para la desinfección de víveres y la cocción a temperatura apropiada de los mismos, buscando evitar la transmisión.
En el concurrido mercado binacional, considerado uno de los puntos de mayor afluencia, también se han intensificado o redoblado las acciones de prevención. Personal de inspección supervisa los productos y reparte boletines informativos relacionados con la manipulación segura de los alimentos.
Finalmente, la funcionaria garantizó que los centros hospitalarios en Dajabón se encuentran preparados para cualquier eventualidad o para responder ante cualquier caso que despierte sospecha de cólera.
“Nos mantenemos listos para ofrecer una respuesta ágil, tal como hemos procedido en eventos previos”, concluyó la doctora Rodríguez.